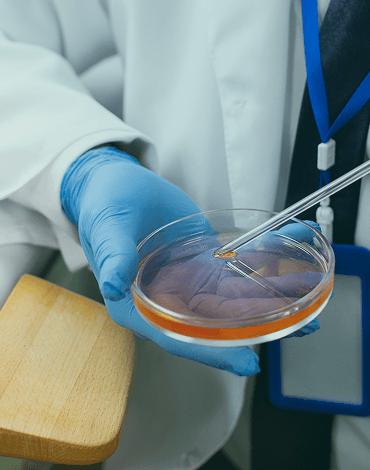
Hormone & Adrenal Testing

Minaam Jamil
Natural Health Practitioner

Philosophy of Care
Holistic menopause care looks at the whole person to ease symptoms and improve long-term health. Instead of focusing only on hot flashes or sleep issues, it considers hormones, nutrition, stress, sleep quality, movement, and overall lifestyle to restore balance.
We prioritize your well-being and follow a holistic approach to create a safe and nurturing environment for your healing journey.
Early Signs to Notice
Personalized holistic menopause care helps relieve hot flashes, sleep issues, mood swings, weight changes, and fatigue restoring balance and well-being.

Sudden feelings of intense heat, often accompanied by sweating, can disrupt daily activities and sleep.
Difficulty falling asleep, staying asleep, or experiencing restless sleep is often linked to hot flashes and hormonal changes.
Emotional fluctuations, anxiety, or feelings of sadness are common due to hormonal shifts.
Changes in vaginal tissue can lead to itching, dryness, or painful intercourse.
A tendency to gain weight, especially around the abdomen, which is often linked to hormonal changes and slower metabolism.
Our Services
We take a personalized approach to menopause, tailoring care to your hormonal needs and symptoms for lasting relief and vitality.
Root Causes We Focus On
Menopause can be challenging—physically and emotionally. We provide natural, personalized care to calm symptoms, restore balance, and help you feel like yourself again.
Support for cycle changes, mood shifts, and hormonal fluctuations during the transition to menopause.

Targeted strategies to rebalance hormones and reduce symptoms of excess estrogen.

Restore energy and resilience by supporting adrenal health and stress response.

Nutritional and lifestyle interventions to strengthen bones and slow bone loss.

Natural solutions to improve sleep quality and regulate circadian rhythms.
Our Approach
At The Natural Healing Haven, we honor menopause as a sacred transition, a time to reclaim vitality, wisdom, and emotional sovereignty.

We use plant-based therapies from phytoestrogens and adaptogens to gemmotherapy and herbal tonics to gently support hormonal balance. These remedies work with your body’s rhythms, not against them, offering a soft nudge toward harmony and vitality.

We advocate for ovarian preservation whenever possible, recognizing that even post-menopause, your ovaries continue to produce hormones that nourish libido, energy, and emotional resilience. Your body holds wisdom; our role is to protect and amplify it.

No harsh detoxes or synthetic quick fixes. We stimulate gentle drainage through the gut, liver, and lymph, using cupping, bitters, and terrain-based support. Every plan is personalized, especially for women navigating thyroid shifts, fatigue, or emotional transitions.

Menopause is a rebirth, not a breakdown. Through lifestyle counseling, faith-based emotional care, and rituals of self-expression, we help women embrace this stage with joy, sensuality, and spiritual depth. Journaling, aromatherapy, and conscious intimacy become tools for transformation.
We use plant-based therapies from phytoestrogens and adaptogens to gemmotherapy and herbal tonics to gently support hormonal balance. These remedies work with your body’s rhythms, not against them, offering a soft nudge toward harmony and vitality.

We advocate for ovarian preservation whenever possible, recognizing that even post-menopause, your ovaries continue to produce hormones that nourish libido, energy, and emotional resilience. Your body holds wisdom; our role is to protect and amplify it.

No harsh detoxes or synthetic quick fixes. We stimulate gentle drainage through the gut, liver, and lymph, using cupping, bitters, and terrain-based support. Every plan is personalized, especially for women navigating thyroid shifts, fatigue, or emotional transitions.

Menopause is a rebirth, not a breakdown. Through lifestyle counseling, faith-based emotional care, and rituals of self-expression, we help women embrace this stage with joy, sensuality, and spiritual depth. Journaling, aromatherapy, and conscious intimacy become tools for transformation.

Why Choose Us
We believe in a patient-first partnership built on trust and expertise. Our goal is to create a foundation for lasting health.
Our Team
Treatment Costs
A comprehensive session to review your health history, concerns, and goals for personalized guidance.
A quick check-in to track progress, adjust protocols, and answer questions.
A therapeutic cupping session to promote detoxification, circulation, and healing.
A tailored plan designed to restore digestive balance and improve overall gut health.
Watch Now
Testimonial

Ask, Learn, Understand
Conventional care often includes HRT and non-hormonal medications with strong evidence. Holistic care complements this by focusing on root contributors nutrition, sleep, stress, movement, and micronutrient status to support your body’s transition. It can be used alongside your clinician’s plan (including HRT) or when HRT isn’t appropriate.
Yes, when appropriate. While we focus on natural therapies, BHRT may be included as part of a personalized plan if it's the right fit for you.
Timelines vary, but many notice improvements within a few weeks. Deeper, lasting changes typically unfold over a few months.
We are an out-of-network provider and do not bill insurance directly. However, we can provide you with a detailed invoice that you can submit to your insurance company for potential reimbursement. We also accept HSA/FSA cards.
LATEST NEWS & Blog
When it comes to your health, feeling “off” can be one of the most frustrating experiences, especial...
Read MoreAre you struggling with persistent fatigue, unexplained aches, or a heavy feeling that rest just won...
Read MoreYour journey to a healthier, more vibrant life starts here. Whether you’re seeking preventive care, natural solutions for chronic conditions, or personalized wellness guidance — we’re here for you.